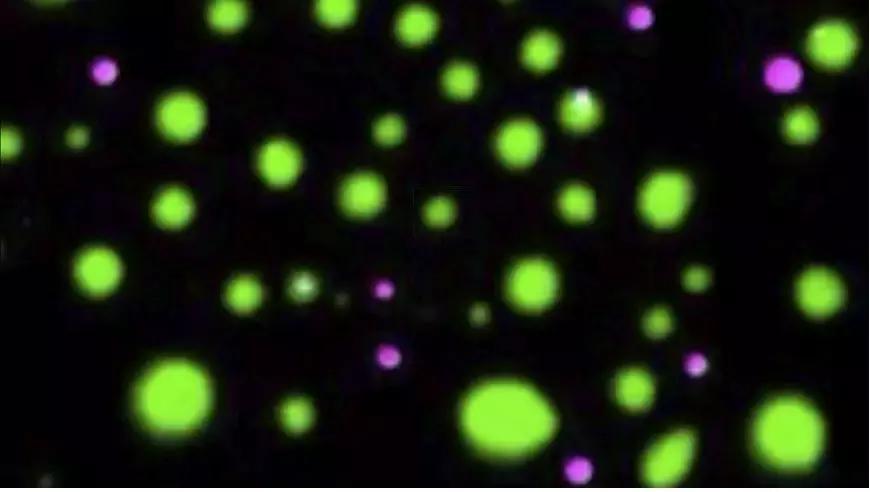
science十大科学突破,science2017全球十大科学突破

当地时间 12 月 20 日,2018 年 Science 杂志最后一期更新,Science 官网公布了 2018 年十大科学突破。其中对多细胞生命发育秘密的揭示,成为 2018 年最重要的科学进展,位居十大科学突破榜首。
其余九大 2018 年最重要的科学发现、进展或趋势分别为:来自遥远星系的中微子、分子“CT”、格陵兰冰原深处的陨石坑、科研界的“MeToo 运动”、古代人类的混血、DNA 侦查、首个 RNA 药物上市、5 亿年前的动物始祖、细胞内的“相分离”。

(图源:Science)
每年 12 月,Science 杂志编辑部都会按照惯例邀请记者、编辑和业界人士推选年度“最佳突破”成就或科学发现,并向广大读者开放投票。因此这一榜单也被认为是“the People's Choice—along with Science's choice”。
值得一提的是,在一开始的候选项中,贺建奎基因编辑婴儿事件也被入选,但后来 Science又将其删除,表示是为了避免给人一种误导,即 Science 杂志认可这种道德上令人担忧的科学进步。
生命发育的秘密

图 | 生命发育(来源:Harvard Medical School)
无论是蠕虫,蓝鲸,还是人类,自然界所有的多细胞生命都是从单个细胞发育而来开始。
这样一个单细胞,鬼斧神工地构建出有机生命体所需的各种组织、器官、系统。每个新细胞在正确的时间,在正确的地方分裂、分化,并与相邻细胞协调精准发挥功能。
多细胞生命的发育过程,是自然界中最引人注目的壮举之一。尽管经过数十年的研究,生物学家仍然无法完全理解这一过程。
2018 年 4 月 26 日,Science 杂志发表三篇超重磅研究,来自哈佛医学院和哈佛大学的研究人员使用多种技术组合,包括对发育中斑马鱼和青蛙胚胎数千个单细胞的基因测序,以精确的方式跟踪和描绘了组织和整个机体从单细胞发育的完整历程。
哈佛大学分子和细胞生物学教授 Alexander Schier 表示,“这几乎就像通过几颗星星看到了整个宇宙。”
使用单细胞测序技术,研究团队在胚胎发育的最初 24 小时内追踪单个细胞的命运,揭示出单个细胞基因开启或关闭的综合景观,以及胚胎细胞何时何地转变为新的细胞状态和类型。
这些发现就好比是勾勒出胚胎发育过程中产生不同细胞类型的遗传“配方”目录,为发育生物学的深入研究和疾病的认识,提供了前所未有的资源。

图 | 斑马鱼受精卵在 4、6、8、10...... 小时(hpf)时的发育过程中不同器官细胞形成,最中心的深蓝色为受精卵,以时间为单位向外辐射(来源:harvard.edu)
“通过单细胞测序,我们可以在一天的时间里概括数十年来对细胞在生命早期阶段分化的艰苦研究。”哈佛医学院系统生物学助理教授 Allon Klein 表示,“通过我们开发的方法,我们正在绘制我们认为发育生物学的未来,发育生物学将会转变为定量的、大数据驱动的科学。”
Alexander Schier 表示,除了对生命早期阶段有所了解之外,这项工作还可以为大量疾病的新认识打开大门。“我们预见,任何复杂的生物学过程,只要是细胞随时间改变了基因表达,都可以使用这种方法重建,不仅仅是发育中的胚胎,还有癌症发生或大脑退化。”
来自遥远星系的中微子
2018 年 7 月 12 日,多国科学家在 Science 发表文章宣布,他们首次确定了发现的宇宙高能中微子,来自于距地球大约 40 亿光年的遥远星系。
中微子,又称“幽灵粒子”,是自然界中广泛存在的一种亚原子粒子,质量极小,几乎不与其他物质作用。由于中微子能自由穿过人体、行星和宇宙空间,难以捕捉和探测,科学家也将它称为宇宙中的“隐身人”。

图 | 位于南极下方的粒子探测器(来源:Jamie Yang and Savannah Guthrie/IceCube/NSF)
2013 年,天文学家宣布利用埋在南极冰下的粒子探测器,首次捕捉到源自太阳系外的高能中微子,但并未追踪到其来源。直到 2017 年 9 月 22 日,位于南极的粒子探测器又捕捉到一个高能中微子,在动用多台陆基和太空望远镜追根溯源后,研究人员发现这个高能中微子来自耀变体 TXS0506+056,即一个中央存在快速旋转大型黑洞的巨大椭圆形星系。
这一耀变体位于猎户座,距地球大约 40 亿光年。进一步研究发现,南极冰下粒子探测器先前发现的一些中微子也来自该耀变体。
这项突破性进展将为认识宇宙提供一种新方法,也将推动多信使天文学(使用电磁波、引力波、中微子、宇宙线中的两种或多种手段对天体进行观测)进入一个新的时代。
分子“CT”
在化学世界里,分子结构决定功能,因此结构鉴定是有机化学早期的核心工作,也是药物研发的重中之重。
来自加州理工学院和加州大学洛杉矶分校的研究人员,通过对冷冻电镜技术的改进,实现可以用极微量样品(百万分之一纳克)、较短时间(几分钟)即可获得高分辨化学结构(<1 埃)。且样品不需是单晶、甚至不需是纯品,而且可以同时测定多个样品结构,因此有人认为这是小分子化学结构鉴定的颠覆性进展。

图 | 基于电子显微镜技术来确定小有机分子的精确形状(来源:Gonen Lab)
“我对此感到震惊,”斯坦福大学化学家 Carolyn Bertozzi 说,“你可以从一个比尘埃小一百万倍的样本中得到这些结构,这简直太美丽了。这是化学新的一天。”
格陵兰冰原深处的陨石坑
根据 2018 年 11 月 Science Advances 发表的一项研究,丹麦自然历史博物馆地质遗传学研究中心的研究人员在格陵兰岛北部的冰盖下发现了一个 31 公里宽的陨石撞击坑。这是第一次在地球大陆冰盖下发现的陨石坑,可能有助于解释一些令人费解的气候变化。

图 | 小行星撞击(来源:NASA's Conceptual Image Lab/Brian Monroe)
研究人员表示,陨石坑口直径超过 31 公里,相当于比整个巴黎更大的面积,也因此成为地球上 25 个最大的陨石坑之一。陨石坑应该是由一个一公里宽的陨石撞到格陵兰岛北部时形成的,后来被一直隐藏在冰层中。
这个巨型圆形凹陷,是在 2015 年 7 月首次发现的。当时研究人员注意到位于格陵兰岛北部冰盖边缘冰川下的一个令人兴奋的但以前未被发现的圆形凹陷,但当时并不能确定其起源。
科研界的“MeToo 运动”
2018 年,Metoo 运动继续保持着强劲势头,仅在今年就有上百名权势人物被指控犯有性侵行为。这场运动在 2017 年成为主流,更多的女性挺身而出,将施虐者绳之以法。

图 | MeToo 运动(来源:Bertrand Guay/AFP/Getty Images)
“MeToo”运动在科学方面也取得了重大进展。一些科研机构揭发了潜藏多年的性骚扰指控事件,包括长期忍受著名科学家的歧视或欺凌。美国国家科学院、工程院和医学科学院联合呼吁进行系统性改革以防止此类性骚扰事件的发生。
古代人类的混血
2018 年 8 月 22 日,德国马克斯普朗克进化人类学研究所的考古团队在 Nature 刊发文章,通过对一枚发现于西伯利亚地区阿尔泰山脉一个洞穴的小女孩骨片 DNA 分析显示,她是两种史前人类尼安德特人(Neanderthal)和丹尼索瓦人(Denisovan)所交配诞下的“混血儿”。
这是研究人员首次发现一个远古的个体,其父母属于不同的人类群体。

图 | 生活在 5 万多年前的女性骨片(来源:Thomas Higham/University of Oxford)
位于伦敦的弗朗西斯·克里克研究所(Francis Crick Institute)的群体遗传学家 Pontus Skoglund 认为,“从这些古人类群体中找到具有混合血统的第一代人,绝对是非同寻常的事。这是一次伟大的科学发现,外加一点点好运气。”
尼安德特人与丹尼索瓦人属远亲,他们的共同祖先约 50 万年前出现,均源自非洲。尼安德特人主要居住在欧洲,丹尼索瓦人则聚居于中亚和东亚。这两个史前人种大约在 4 万年前就已消失,研究人员普遍认为,丹尼索瓦人是因疾病或气候转变而导致灭绝。
此外,现代智人大约在 5 万年前离开非洲大陆,迁徙到全世界,他们也与尼安德特人、丹尼索瓦人彼此交配,生下混种后代。科学家们仍在不断探索这关于两个人种的秘密。
DNA 侦查
2018 年 4 月,美国加州警方通过 DNA 数据库,在加州首府萨克拉门托附近的西特勒斯海茨市(Citrus Heights)逮捕了一名 72 岁退休警员 DeAngelo,指控他涉嫌在上世纪七八十年代犯下一系列强奸和谋杀案,并认为他就是当时轰动一时的金州杀手 (Golden State Killer),也被称为东区强奸犯 (East Area Rapist)。

图 | 臭名昭着的金州杀手(来源:Paul Kitagaki Jr./The Sacramento Bee/AP Images)
自 4 月份第一例悬案解决以来,美国 DNA 刑侦的洪闸已打开,多例“悬案”正在以一种创纪录的速度被解决。在这些案件的破解过程中,调查人员可以将长期未能结案的强奸谋杀案遗传学证据输入了可公开访问的 DNA 数据库中,然后系谱学家可以用遗传信息匹配远亲以找到可能的嫌疑人,这种侦查结合了 DNA 数据、出生记录和社交媒体资料。
系谱学家们也给出预测,很快将可利用 DNA 数据库解决数以百计的罪案。
首个 RNA 药物上市
2018 年 8 月 10 日,美国食品药品管理局(FDA)批准了首个基于 RNA 干扰(RNAi)机制的药物,Alnylam 公司研发的 Onpattro(patisiran),用于治疗遗传性转甲状腺素蛋白淀粉样变性(hATTR)引起的神经损伤。
这是在 RNAi 机制被发现 20 年后首次面世的创新类药物,也是 FDA 批准的首个治疗该适应症的药物。

图 | 首个 RNAi 药物进入临床(来源:V. Altounian/Science)
hATTR 是一种严重而致命的罕见遗传性疾病,全球约有 5 万名患者受此疾病影响。患者从发病起,预期寿命只有 2-15 年。
hATTR 是由 TTR 基因突变导致,TTR 蛋白通常在肝脏产生,在 TTR 基因上发生的突变会造成异常淀粉样蛋白沉积,进而损伤包括外周神经和心脏在内的身体器官和组织,诱发外周感觉神经病变、自主神经病变、和心肌病等疾病。目前,hATTR 患者的治疗选择十分有限,往往只能在疾病早期进行肝脏移植手术。
1998 年,斯坦福大学的 Andrew Fire 教授和马萨诸塞大学的 Craig Mello 教授在线虫中发现 RNAi 现象,对其进行研究并转化成一种实用的基因调控技术,他们也因此荣获 2006 年的诺贝尔生理学或医学奖。
许多人看到了 RNAi 技术抑制致病蛋白表达从而实现疾病治疗的光明前景,也正是在那个时候,出现了众多以 RNAi 技术治疗疾病的生物技术创业公司。
但是直到 2018 年,首个基于 RNAi 机制的药物才终于问世。也许,Onpattro 的上市,将会真正开启 RNAi 药物这个领域的未来。
5 亿年前的动物始祖
2018 年 9 月,Science 杂志发表的一项研究指出,科研人员在一块距今 5.58 亿年前生物化石中发现了胆固醇分子,从而确认这种生物是地球上已知最古老的动物之一。
这块化石在俄罗斯西北部海域附近发现,由于时间过于遥远,无人能辨识它的身份,因此该化石也被学界称为“古生物学圣杯”。澳洲国立大学地球科学研究所副教授 Jochen Brocks 表示,科学家超过 75 年来对这怪异化石的本质争论不休。

图 | 5 亿年轻的动物(来源:D. Grazhdankin)
据介绍,这种被称为 Dickinsonia 的椭圆形生物长 1.4 米,全身有肋骨状结构,属于埃迪卡拉生物群,这类生物比 5.4 亿年前“寒武纪大爆发”中出现的大量动物还早了近 2000 万年。
这证明当时的动物群大而丰富,比此前估计的还要早。此前假说认为,节肢动物在 5.4 亿年前的寒武纪“突然”出现,但也有研究者猜测,节肢动物在寒武纪之前应该已经开始缓慢进化,只是因为那个时期的化石难以保存,才始终没有找到确切证据。
研究人员表示,Dickinsonia 化石是一把钥匙,有助于理解以细菌为主的世界如何演化到“寒武纪大爆发”后的大型动物世界。
细胞内的“相分离”
2018 年,有关细胞内“相分离”(Phase separation)的研究文章不断出现。越来越多的证据表明,细胞成分会凝结成微小液滴,从而发挥关键功能。研究人员发现,细胞内相分离现象在基因转录中的意外作用,以及溶解固定液滴的可能途径,并且有可能会阻碍肌肉在肌萎缩侧索硬化等疾病中的作用。
早在 1899 年,美国细胞生物学家 Edmund Beecher Wilson 就提出细胞质可能包括“多种液体的混合”,其中有“不同化学性质的悬浮液滴”。之后,研究人员开始探索“相分离”是否可能与疾病或者细胞构架相关。
2017 年麻省理工学院的研究人员曾在 Cell 杂志上发表观点性文章,提出了一个以相分离理论解释超级增强子参与基因调控的模型,但没有直接的实验证据。
图 | 细胞内相分离(来源:E. M. Langdon et al., Science 2018)
2018 年 6 月,研究人员在 Science 发表文章,报道了转录共激活因子 BRD4 和 MED1 可以在超级增强子处发生相分离形成液滴。这项研究为超级增强子通过相分离调控基因表达的模型提供了实验证据,也对细胞命运决定和疾病发生过程中关键基因的表达调控过程提供了全新的视角和概念。